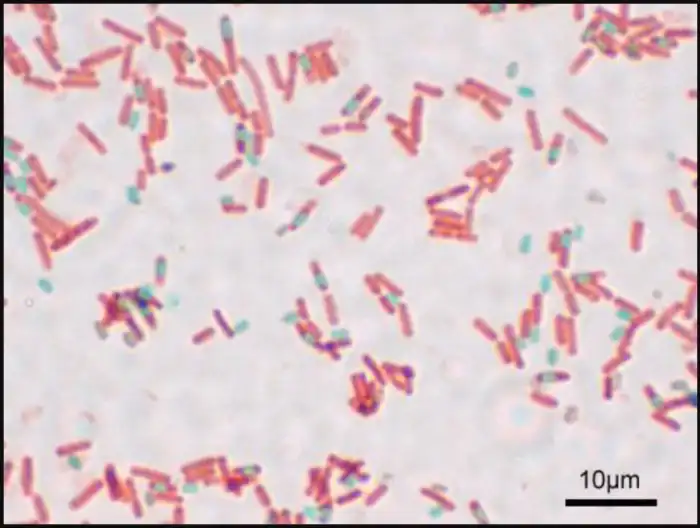

Туарегская женщина. Источник изображения: dear-eva.gr
Действенность этого средства арабской народной медицины была отмечена западными учеными в конце тридцатых - начале сороковых годов прошлого века. Иностранные войска, расквартированные в Африке во время Второй мировой войны, несли значительные потери от дизентерии, в то время как местные кочевники от болезни не страдали вовсе.
Медики, проведя несложное расследование, установили, что эта «неуязвимость» достигается благодаря употреблению в пищу испражнений кораблей пустыни. Причем они не должны быть каким-то образом высушены, покрыты шоколадом, растворены в травяном чае с добавлением лимона...
Для предотвращения дизентерии необходим совершенно свежий верблюжий навоз - теплый, прямо, если так можно выразиться, из источника :)
Дальнейшие исследования показали, как работает эта крайне специфическая субстанция. Все дело в содержащихся в ней бактериях. В частности, речь идет о сенной палочке (Bacillus subtilis), которая была идентифицирована в 1835 году. Её обнаружили в сене, но сегодня она считается почвенным микробом.
Это близкая родственница сибиреязвенной палочки (Bacillus anthracis), но, к счастью, к человеку она относится весьма мягко, где-то даже снисходительно. При этом она крайне агрессивна к другим микробам и именно по этой причине идеально подходит для лечения той же дизентерии.
Клетки Bacillus subtilis (споры окрашены в синий цвет). Источник изображения: wikimedia.org
Сенная палочка выделяет антибиотики, уничтожающие, например, шигеллы - бактерии, вызывающие дизентерию. Установлено, что гены, ответственные за производство этих веществ, составляют до пяти процентов генома B. subtilis. Кроме того, исследования показывают, что наличие сенной палочки в человеческом кишечнике каким-то образом стимулирует иммунную систему, позволяя ей эффективнее бороться с желудочными патогенами. Клинические испытания продемонстрировали, что этот микроб превосходно лечит диарею.
Въедливый читатель может задать пару резонных вопросов:
«Если сенная палочка считается почвенным микробом, почему её непременно нужно принимать вовнутрь в составе такой неприятной на вкус и запах субстанции, как верблюжий навоз? Разве нельзя съесть чуточку сена или, на худой конец, земли?»
Конкретно в такой постановке эта проблема исследователями не изучалась. Однако установлено, что концентрация сенной палочки в навозе с течением времени уменьшается, а количество тех же грибков, наоборот, растет. Кроме того, чем в более сухой среде находятся B. subtilis, тем меньше вероятность, что они размножатся в требующемся объеме внутри кишечника. Свежий навоз, особенно верблюжий, богат бактериями. В пищеварительной системе этих животных огромное разнообразие бацилл.
Некоторые ученые считают, что микробы эволюционно приспособились к жизни в данной среде и стали приносить огромную пользу травоядным - они производят ферменты, помогающие животным расщеплять жесткую растительную пищу.
Колония B. subtilis (сенной палочки). Источник изображения: biologydictionary.net
В наше время бактериальная дизентерия лечится антибиотиками, а не порцией верблюжьего навоза. Даже в тех местах планеты, где последнее было когда-то распространенной традицией. Тем не менее, актуальность сенной палочки не стала меньше. Она применяется в качестве пробиотика. Бактерии выращиваются в лабораториях и упаковываются в капсулы, не имеющие посторонних вкусов и запахов. Микробы превосходно размножаются в соответствующей среде, и с какого-то времени используются в качестве модельных организмов. Это значит, что они уже внесли весомый вклад в науку.
Исследуя эти бактерии, ученые многое узнали о фундаментальных клеточных процессах, например, о механизме деления. В общем, сенная палочка оказалась невероятно полезной. Она не только спасла от мучительной смерти миллионы людей, но и помогла в изучении биологической жизни как таковой.